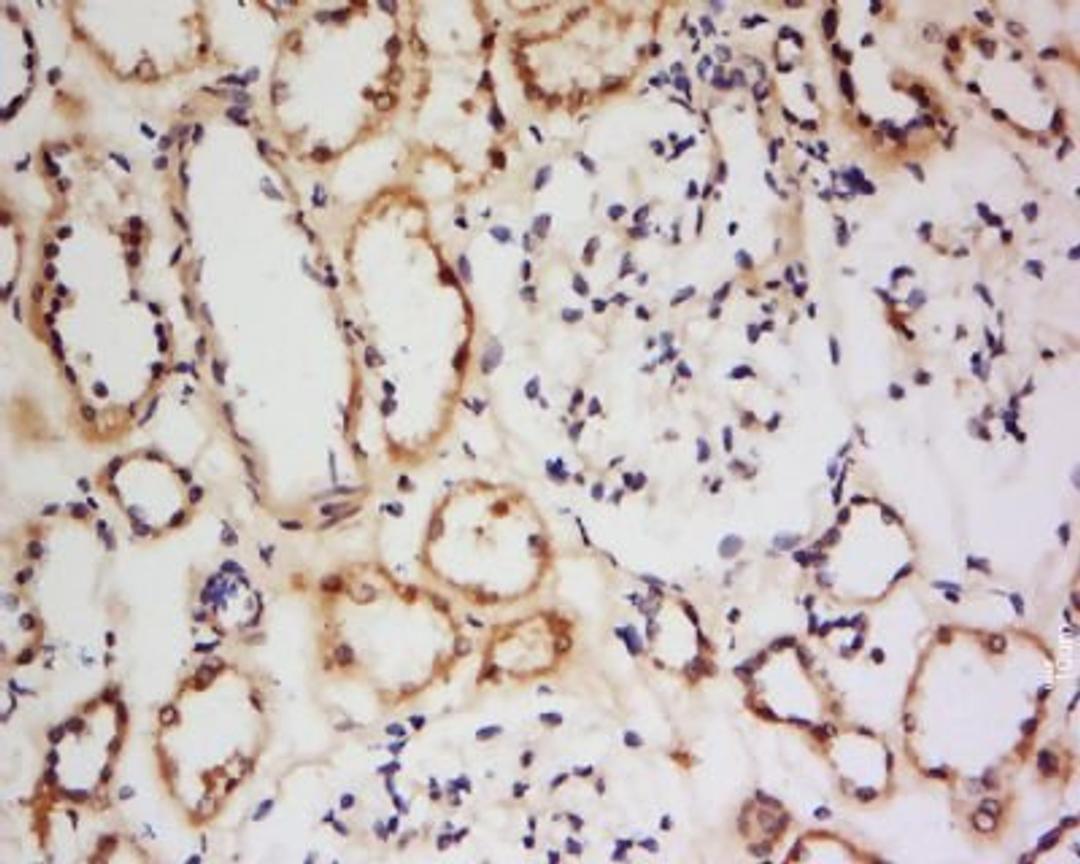
Immunohistochemical staining of human kidney tissue using CNGB3 antibody.

Product & ReviewsAntibodies
Claudin 19 antibody
Product Details
- Cat. No.
- orb156388
- Type
- Primary Antibody
- Clonality
- Polyclonal
- Host
- Rabbit

The supplier does not provide quotations for this antibody through SelectScience. You can search for similar antibodies in our Antibody Directory.
Description
Rabbit polyclonal antibody to Claudin 19.
Biological Information
- Clonality: Polyclonal
- Host: Rabbit
- Reactivity: Human, Mammalian, Mouse
- Isotype: IgG
- Gene: 2557
Handling
- Quantity: 100 µg, 200 µg
- Storage: Store at 4°C for one month and at -20°C for a longer time. Avoid repeated freezing and thawing.
- Buffer: 0.01M TBS (pH7.4) 0.5% BSA 0.015% Proclin300 25% glycerol
Applications
- ELISA (ELISA)
- Immunohistochemistry (Paraffin-Embedded Sections) (IHC (P))
- Western Blotting (WB)